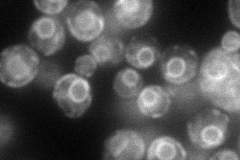
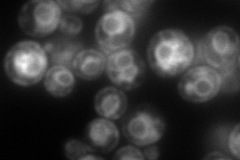
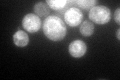
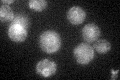

View description
Transmembrane protein subunit of the glycosylphosphatidylinositol transamidase complex that adds GPIs to newly synthesized proteins; human PIG-Sp homolog
Localization:
Intensity:
Fold change:
Significance:
-
C’ GFP library in SD

ER32.21 -
N' NOP1pr-GFP in SD
ER95.8735 -
N' TEF2pr-mCherry in SD
ER,vacuole173.228 -
N' NATIVEpr-GFP in SD

ambiguous,ER24.9705 -
N' TEF2pr-VC and Cyto-VN in SD

below threshold29.1614 -
C’ GFP library in SD+DTT
ER59.631.85Yes -
C’ GFP library in SD+H2O2

ER29.70.92No -
C’ GFP library in Starvation Media
ER29.590.91No -
C’ GFP library on the background of Pup2-DaMP

ER -
C’ GFP library on the background of CCT mutant

ER33.77331.04829No
